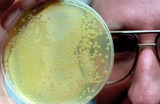
Палочка, да не та: немцы реабилитировали испанские огурцы

Обновлено

К Онищенко возвращается вера в европейские овощи
Роспотребнадзор разрешил ввозить в Россию овощи уже из четырех европейских стран, два дня назад сняв запрет с Нидерландов и Бельгии, а сегодня — с Дании и Испании. В листе ожидания — Польша, Литва и Чехия